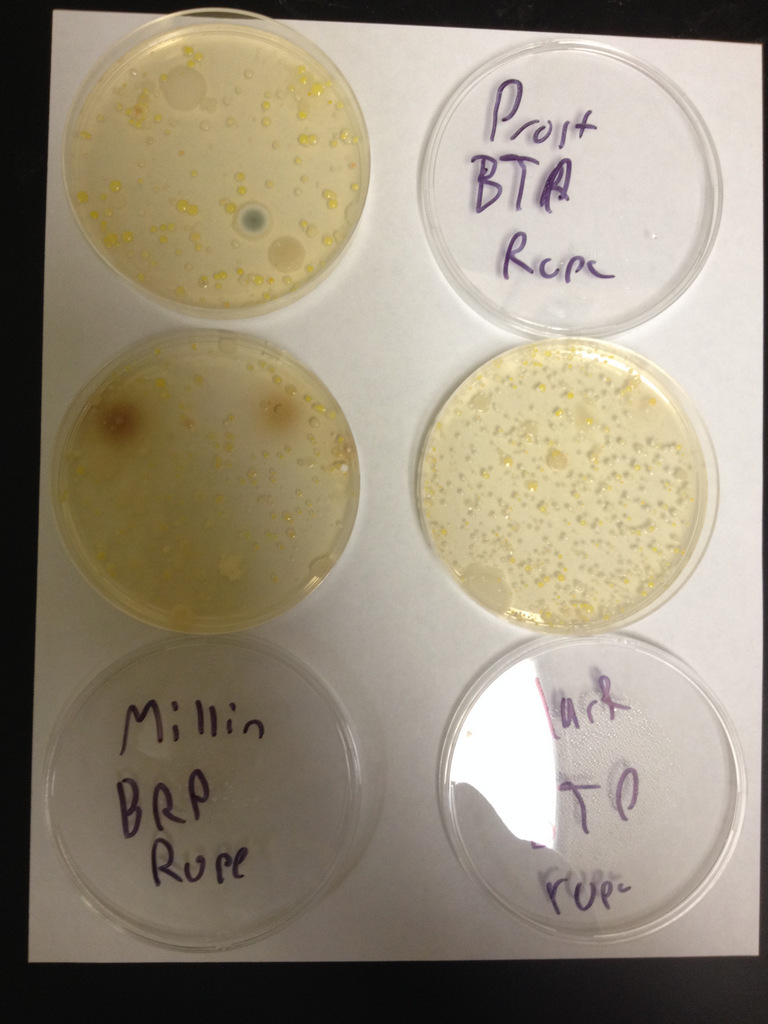

How nasty are the bathroom passes?
By Justin Scherzer, Current Staff
Everything you touch in the school is filthy.
This is the finding of a December experiment conducted by The Current and biology teacher Daniel Millin. The goal of the experiment was to determine whether the school’s bathroom passes are really as gross as students suspect them to be.
“I find them disgusting and annoying. Sometimes even when I really have to go, I don’t use the bathroom passes because they’re too gross,” Emily Kolb, an East freshman, said.
“I feel like they’re unsanitary. The bathrooms are already gross enough, and I don’t feel comfortable with holding something that is always touching the bathrooms,” East freshman Auburn Larson said.
Turns out, the passes are indeed very gross. But no more so than anything else in the school.
Although the idea of touching microscopic bits of other people’s waste leftover on the bathroom passes is nothing short of revolting, it really is not that much worse than putting your hands on your desk, using a school computer, or even opening a door.
With the hesitation many students have shown towards the mandatory hall passes, the question was raised: Just how disgusting are they, in comparison to other commonly touched objects around the school? East biology teacher Daniel Millin helped The Current construct an experiment in order to test this through the use of bacteria cultures, in order to be able to compare the total amount of bacteria on each tested object.
Millin supplied petri dishes filled with agar in order to conduct the experiment. Several of each tested items were swabbed and transferred onto the dish and then put in an incubator for several days, growing the bacteria and making it visible, so it could be determined how much bacteria was in each sample.
Above all else, the results of the experiment showed that students should be just as worried about various other commonly used items around the school.
The experiment began by testing hall passes. Both the lanyard (Picture 1) and the main section (Picture 2) were tested on three separate hall passes, and they all showed varying amounts of bacteria. The main section of Mr. Prost’s pass proved to have the most bacteria growth, but as for the lanyard, Mr. Clark’s pass clearly had the majority. Prost and Clark are both East science teachers.
The outcome of the amount of growth on each pass was not consistent, which was to be expected considering that the amount of use will vary on a class by class basis. However, this same finding can be applied to most other objects in the school.
Two desks were tested (Picture 3), and although one of the desks exhibited far less bacteria than the passes, the amount on the other desk had an amount that was seemingly equivalent to the passes.
Even if only a small percent of desks are dirty to this extent, every student sits at numerous desks throughout the day, and the desks they sit at sometimes vary day to day. This means that on multiple occasions, a vast majority of students will unknowingly sit at desks that have the same amount of bacteria as an item that spends much time in the bathroom.
In addition, two library keyboards were tested (Picture 4), both showing an extremely similar amount of bacteria to the passes. Keyboard #1 showed more growth than a majority of the bathroom passes, and keyboard #2 seemed to have a similar amount.
The pattern continued when door handles were tested (Picture 5), where both had an almost identical amount of bacteria as the bathroom passes.
Because these are several of the most commonly used objects throughout the school, they show that it might be best for students not be any more disturbed about the condition of the hall passes than they are about anything else they come in contact to throughout the day.
“I expected this to happen. Bacteria is all around us, and it is unlikely that fecal matter or any excess amount of bacteria would be on the passes in comparison to anything else,” Millin said.
(Photographs by Justin Scherzer, Current Staff.)






Leave a comment